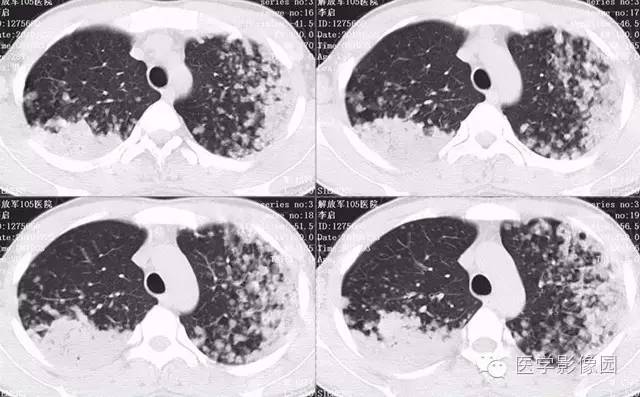
【病例】弥漫性肺泡细胞癌1例CT影像表现

弥漫性肺泡细胞癌1例CT影像表现
发布时间:2022-11-27
发布时间:2022-11-27

病理结果:弥漫性肺泡细胞癌
弥漫性肺泡癌的主要临床及CT表现:临床表现无明显特征, 随着病情的进展, 咳嗽、 咳白痰、 进行性气促。CT表现 为病变分布有两种情况:病变累及一个肺段或肺叶;病变广泛分布于两肺。可归纳为5个特征性征象:蜂房征;支气管充气征;磨玻璃征;血管造影征;两肺弥漫分布的斑片状与结节影。
上一篇:胸部常见疾病的CT基本征象
下一篇:胸片肺野透过度增强,想到什么病